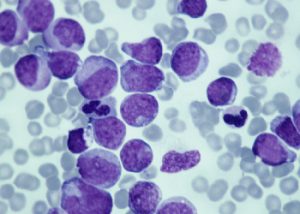

塞利尼索片在抗癌治疗中发挥着多重作用,它不仅能有效遏制癌细胞的增殖,还能显著提升机体的免疫功能,并有助于降低肿瘤的耐药性。对于淋巴瘤和多发性骨髓瘤患者而言,服用塞利尼索片可以阻止致癌因子从细胞核内向外运输,从而减少新的癌细胞产生,有效抑制癌细胞的扩散和转移。
印度塞利尼索价格
印度塞利尼索的价格,目前市场上一盒的售价大约在3980至4000元之间,每盒包含20mg*16片的剂量。这一价格的设定,无疑为广大患者带来了福音。在过去,高昂的塞利尼索费用常常让许多家庭背负沉重的经济压力。
印度塞利尼索哪里买
一是亲自前往印度,直接在当地的药店购买;
二是通过线上的海外医疗服务机构进行代购,比如印度维耐海外医疗,他们提供从印度药房直接邮寄到家的服务。您可以通过(微信:wndg91)与他们联系,享受便捷的直邮服务。
